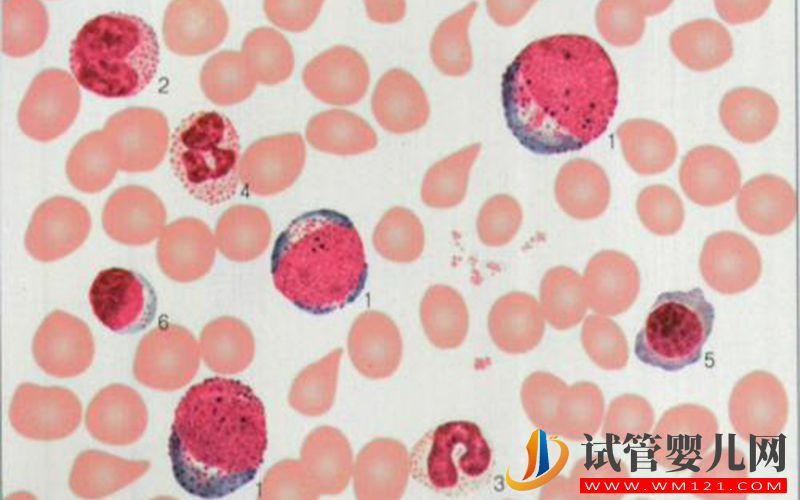
在美國les用骨髓技術生孩子要多少錢？(圖1)

?
欧美电影网站|
亚洲欧美高清|
成人h在线播放|
免费在线观看a|
日本一区二区三区dvd视频在线|
国产综合免费视频|
2020国产在线视频|
亚洲成人xxx|
一二三区免费视频|
亚洲大片在线|
日韩av免费电影|
中文字幕视频在线免费|
在线一区二区三区|
欧美成人精品欧美一|
日韩成人激情|
国产精品一区二区在线观看|
精产国产伦理一二三区|
偷拍一区二区三区|
国产精品69久久久久孕妇欧美|
日韩mv欧美mv国产网站|
国产日韩一区在线|
av在线影音|
亚洲五码中文字幕|
亚洲精品成人av久久|
国产成人一区|
91免费在线观看网站|
又黄又爽又色视频|
动漫精品一区二区|
欧美日韩在线观看免费|
午夜精品一区二区三区国产|
精品国产日本|
伊人75在线|
91精品欧美综合在线观看最新
|
欧美黄色一区|
色噜噜狠狠一区二区三区|
污网站视频在线观看|
欧美一区二区久久|
亚洲综合成人av|
免费不卡在线观看|
九九九九免费视频|
自拍偷拍亚洲视频|
欧美国产第一页|
国产精品剧情一区二区三区
|
日韩videos|
电影在线一区|
亚洲乱码国产乱码精品精|
亚洲第一成年人网站|
丰满放荡岳乱妇91ww|
午夜两性免费视频|
97精品资源在线观看|
国产精品成人免费电影|
成人看片app|
欧美曰成人黄网|
蜜臀精品一区二区三区|
免费观看久久久4p|
久久精品网站视频|
国产精品99精品一区二区三区∴|
欧美在线性爱视频|
麻豆视频免费网站|
欧美在线观看视频一区二区
|
国产在线一区观看|
91小视频在线播放|
超碰在线一区|
成人av片网址|
飘雪影院手机免费高清版在线观看|
精品国产一区二区三区不卡
|
无码人妻精品一区二区三区在线|
欧美色片在线观看|
国产精品成人一区|
全部孕妇毛片丰满孕妇孕|
欧美一区二区三区公司|
www.亚洲天堂.com|
久久综合久久综合久久|
亚洲第一成人网站|
91精品啪在线观看国产18
|
欧美xxxx性xxxxx高清视频|
亚洲女女做受ⅹxx高潮|
麻豆chinese极品少妇|
欧美专区一区二区三区|
麻豆传传媒久久久爱|
日本一区二区三区视频在线看|
114国产精品久久免费观看|
深夜福利在线观看直播|
国产香蕉一区二区三区在线视频|
理论片影音先锋|
亚洲一区二区三区四区在线免费观看|
国产亚洲成人av|
美女视频第一区二区三区免费观看网站|
亚洲成人av免费看|
欧美三级午夜理伦三级在线观看
|
欧美福利网址|
www插插插无码视频网站
|
特黄特黄一级片|
精品视频日韩|
黄色网zhan|
欧美日韩国产网站|
亚洲va欧美va国产综合久久|
国产小视频在线|
久久天天躁日日躁|
成年网站视频|
日韩精品一区二区三区在线|
区日韩二区欧美三区|
日韩成人免费看|
2025韩国理伦片在线观看|
欧美黑人巨大videos精品|
欧美亚洲免费在线|
成年男女免费视频网站不卡|
国产精品国模在线|
亚洲一区二区三区精品中文字幕|
亚洲视频在线观看免费|
亚洲精品自产拍在线观看app|
亚洲国产中文字幕|
日本精品入口免费视频|
久久在线观看免费|
欧美三级日本三级|
久久国产三级精品|
国产精品福利导航|
亚洲国产91|
最新国产黄色网址|
日韩免费一区|
欧洲黄色一级视频|
五月天亚洲色图|
日韩视频 中文字幕|
伊人久久大香|
欧美一区二区三区成人久久片|
国产美女精品写真福利视频|
成人午夜激情网|
美女黄视频在线观看|
日本电影亚洲天堂|
男男电影完整版在线观看|
欧美高清在线观看|
久久精品无码一区二区日韩av|
亚洲欧美在线一区二区|
黄色影院在线观看|
亚洲аv电影天堂网|
国产不卡精品一区二区三区|
制服丝袜国产精品|
色精品一区二区三区|
欧洲激情一区二区|
中国人xxxxx69免费视频|
日韩欧美国产黄色|
色噜噜在线播放|
欧美性猛交99久久久久99按摩|
性生活黄色大片|
精品久久久中文|
亚洲不卡免费视频|
精品久久久久久久久中文字幕
|
色哟哟网站入口亚洲精品|
free性欧美1819hd|
色噜噜狠狠色综合网图区|
爆操妹子视频在线观看|
久久激情视频久久|
97影院手机在线观看|
欧美黑人国产人伦爽爽爽|
最美情侣韩剧在线播放|
欧美精品999|
久香视频在线观看|
日本国产欧美一区二区三区|
日本高清视频在线观看|
国产在线视频一区|
久草在线视频福利|
国产精品中出一区二区三区|
新片速递亚洲合集欧美合集|
日本精品一区二区三区视频
|
久久国产欧美|
丰满少妇一区二区|
精品在线一区二区三区|
日韩在线一卡二卡|
caoporen国产精品视频|
精品成人久久久|
国产精品视频你懂的|
一级爱爱免费视频|
午夜国产精品影院在线观看|
香港三日本三级少妇66|
欧美精品久久99久久在免费线|
国产免费黄色|
精品视频一区在线视频|
16—17女人毛片毛片|
欧美xxxx18性欧美|
国产资源在线看|
国产中文字幕亚洲|
天堂在线中文网官网|
亚洲二区三区四区|
女同另类激情重口|
wwwwxxxx日韩|
亚洲精品在线二区|
av男人的天堂av|
懂色av一区二区三区蜜臀|
日韩av黄色片|
亚洲精品一二三|
无码国产精品一区二区免费16|
欧美日本精品一区二区三区|
日本www高清|
日韩在线中文字幕|
男女污视频在线观看|
国产精品色婷婷视频|
蜜桃视频在线观看播放|
亚洲va久久久噜噜噜久久狠狠|
精品综合久久88少妇激情|
欧美性猛交久久久乱大交小说|
国语精品一区|
国产黄色大片免费看|
av午夜一区麻豆|
中文字幕福利视频|
日本道色综合久久|
日本黄色入口|
久久精品99久久香蕉国产色戒|
日本人妖在线|
亚洲自拍偷拍一区|
成人影院网站ww555久久精品|
你真棒插曲来救救我在线观看|
欧美成人中文|
丁香花五月婷婷|
久久这里都是精品|
丰满人妻一区二区三区四区53|
欧美精品久久久久久久久老牛影院|
wwwxx免费|
久久人人爽国产|
国产在线1区|
蜜桃av噜噜一区二区三|
亚洲精品中文字幕99999|
男男受被啪到高潮自述|
国产精品一级片在线观看|
超碰在线观看91|
色综合久久久久网|
三级全黄视频|
欧美激情精品久久久久久蜜臀
|
午夜电影一区二区三区|
国产精品178页|
久久久国产一区二区三区|
国产调教视频在线观看|
欧美午夜精品久久久久免费视|
亚洲国产网址|
国产污在线观看|
99久久99精品久久久久久
|
成人影院中文字幕|
久久久久久久久久毛片|
国产乱码精品一品二品|
亚洲一级在线播放|
制服丝袜成人动漫|
99re6热在线精品视频播放|
91精品在线影院|
91精品国产自产在线丝袜啪|
国产精品久久久久久9999|
国产激情视频一区二区三区欧美|
中文字幕日日夜夜|
91精品国产免费|
黄色直播在线|
国产精品免费一区二区|
亚洲系列另类av|
99久久国产精|
国产欧美日韩三区|
久在线观看福利视频|
日韩中文字幕视频|
国产乱码在线|
无码人妻少妇伦在线电影|
久久亚洲风情|
无码人妻av免费一区二区三区
|
jizzzz日本|
粉嫩久久99精品久久久久久夜|
99热在线只有精品|
精品视频一区在线视频|
午夜在线免费观看视频|
一本一生久久a久久精品综合蜜|
欧美日韩国产高清|
国产亚洲色婷婷久久99精品|
在线免费观看成人短视频|
韩国版免费三体|
超碰在线观看97|
国产一区二区区别|
国产又粗又长免费视频|
亚洲综合丝袜美腿|
成年人三级网站|
国产欧美在线视频|
久久中文字幕导航|
无码h肉动漫在线观看|
亚洲日本va午夜在线影院|
尤物视频在线视频|
国产精品久久久久99|
国产精品久久久网站|
亚洲av无码国产精品久久|
亚洲人成伊人成综合网小说|
色啪啪.com|
国产精品在线看|
欧美日韩一区二区三区在线电影|
wwwwxxxx国产|
亚洲国产成人精品视频|
午夜网站在线观看|
国产精品区一区二区三在线播放|
久久伦理在线|
久久国产精品波多野结衣|
欧美色国产精品|
日韩电影免费|
性欧美18一19内谢|
免费久久精品视频|
成人乱码一区二区三区|
www.亚洲男人天堂|
亚洲综合av一区二区三区|
91蝌蚪视频在线|
国产精品蜜臀av|
wwwxx在线观看|
风间由美久久久|
亚洲精彩视频|
www.色国产|
亚洲精品一区中文字幕乱码|
超碰在线97国产|
中文av一区二区三区|
国产视频911|
美女福利视频导航|
亚洲在线免费视频|
亚洲午夜精品一区二区国产
|
欧美精品一区二区三区蜜桃视频|
av在线官网|
熟女少妇精品一区二区|
久久婷婷色综合|
奇米影视狠狠狠|
97影院在线午夜|
欧美国产高清|
亚洲中文无码av在线|
国产一区二区三区在线观看视频|
gay欧美网站|
亚洲免费观看在线|
亚洲国产综合视频在线观看|
高清免费观看在线|
男女啪啪的视频|
国产高清精品网站|
精品全国在线一区二区|
国产美女91呻吟求|
91高清一区|
日批视频免费观看|
日韩亚洲在线观看|
www欧美在线观看|
日韩免费成人av|
欧美无乱码久久久免费午夜一区
|
不要播放器的av网站|
中文一区二区在线观看|
午夜大尺度福利视频|
日韩av高清|
激情图片小说一区|
精品国产免费第一区二区|
91欧美激情另类亚洲|
欧美99久久|
97超碰中文字幕|
欧美国产第一页|
天海翼精品一区二区三区|
亚洲一区二区91|
亚洲人成伊人成综合网久久久|
69堂精品视频在线播放|
亚洲综合欧美综合|
欧美一激情一区二区三区|
波多野结依一区|
日本少妇激三级做爰在线|
性做久久久久久久免费看|
麻豆app在线观看|
韩国日本在线视频|
亚洲日本丝袜连裤袜办公室|
视频黄页在线|
日本网站免费在线观看|
欧美国产激情一区二区三区蜜月|
国产激情二区|
日韩久久久久久久久久久久|
久久婷婷色综合|
国精产品999国精产品官网|
欧美xxxx吸乳|
99久久亚洲一区二区三区青草|
黄色小视网站|
亚洲午夜精品一区二区|
懂色av一区二区夜夜嗨|
岛国片在线看|
在线免费一区|
91视视频在线观看入口直接观看www|
jizz免费观看|
美女黄色片网站|
久久这里只有精品视频网|
国产九一视频|
www.日本在线播放|
中文字幕在线播放不卡一区|
一二三在线视频社区|
日本熟妇人妻xxxxx|
亚洲精品日日夜夜|
高清美女视频一区|
91插插插影院|
91福利小视频|
春色校园综合激情亚洲|
亚洲av无码一区二区三区人|
日韩欧美第一区|
青青国产精品|
国产亚洲色婷婷久久99精品|
日韩在线欧美在线|
国产成人三级|
国产男女无套免费网站|
国产精品av在线|
在线一区免费观看|
久久国产综合视频|
欧美日韩电影一区二区|
a美女胸又www黄视频久久|
日本电影免费看|
日本黄色三级大片|
天天色 色综合|
a√中文在线观看|